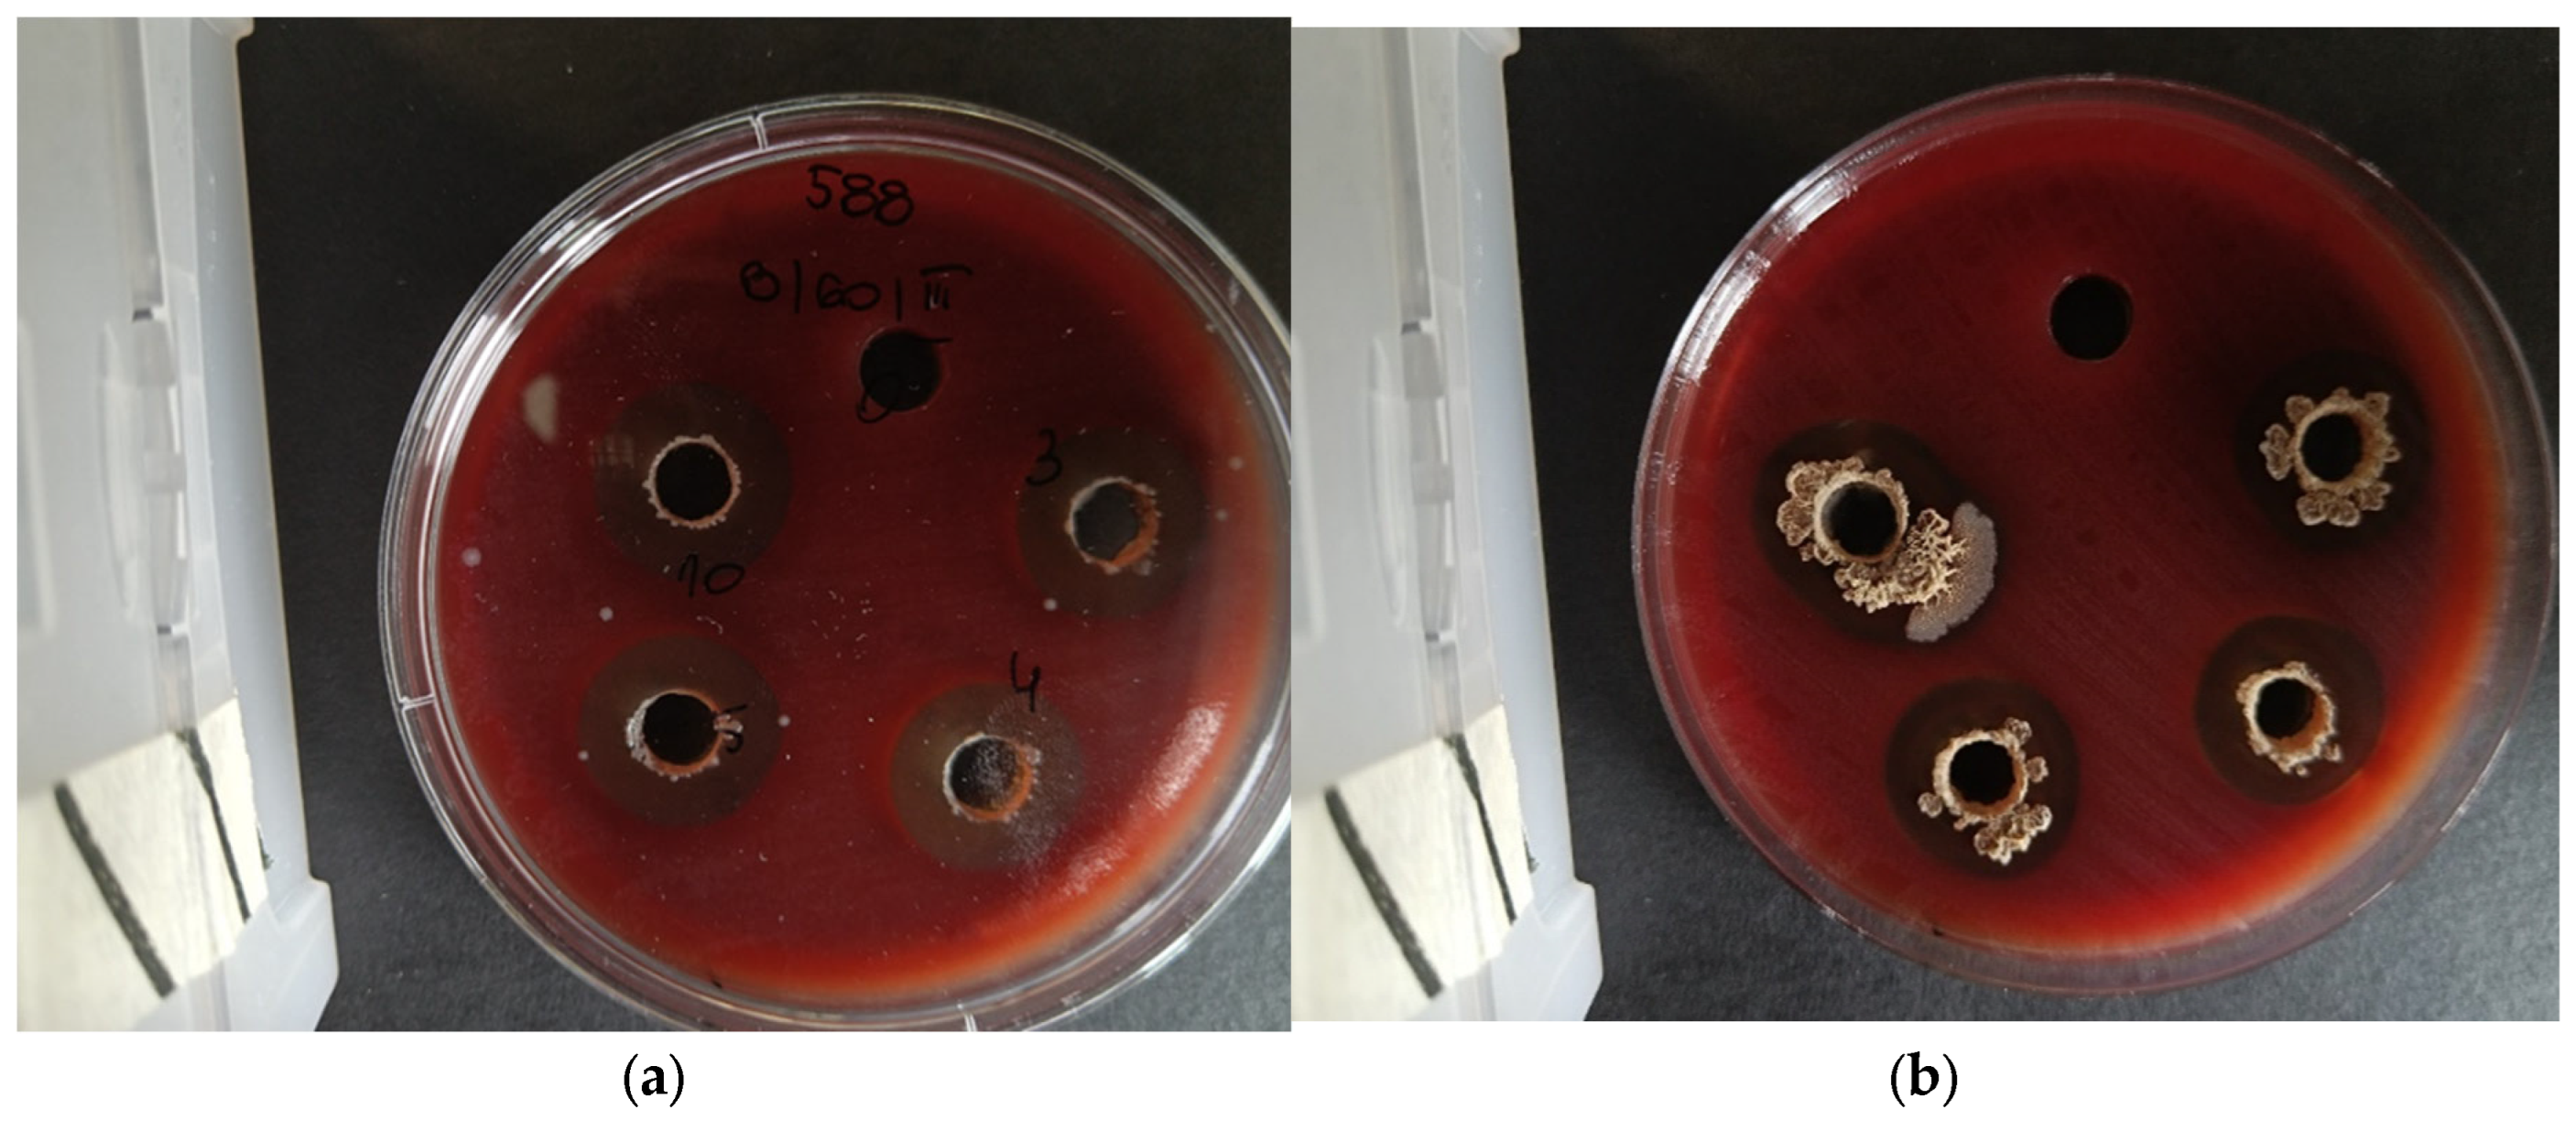
Preprints 119735 g003a
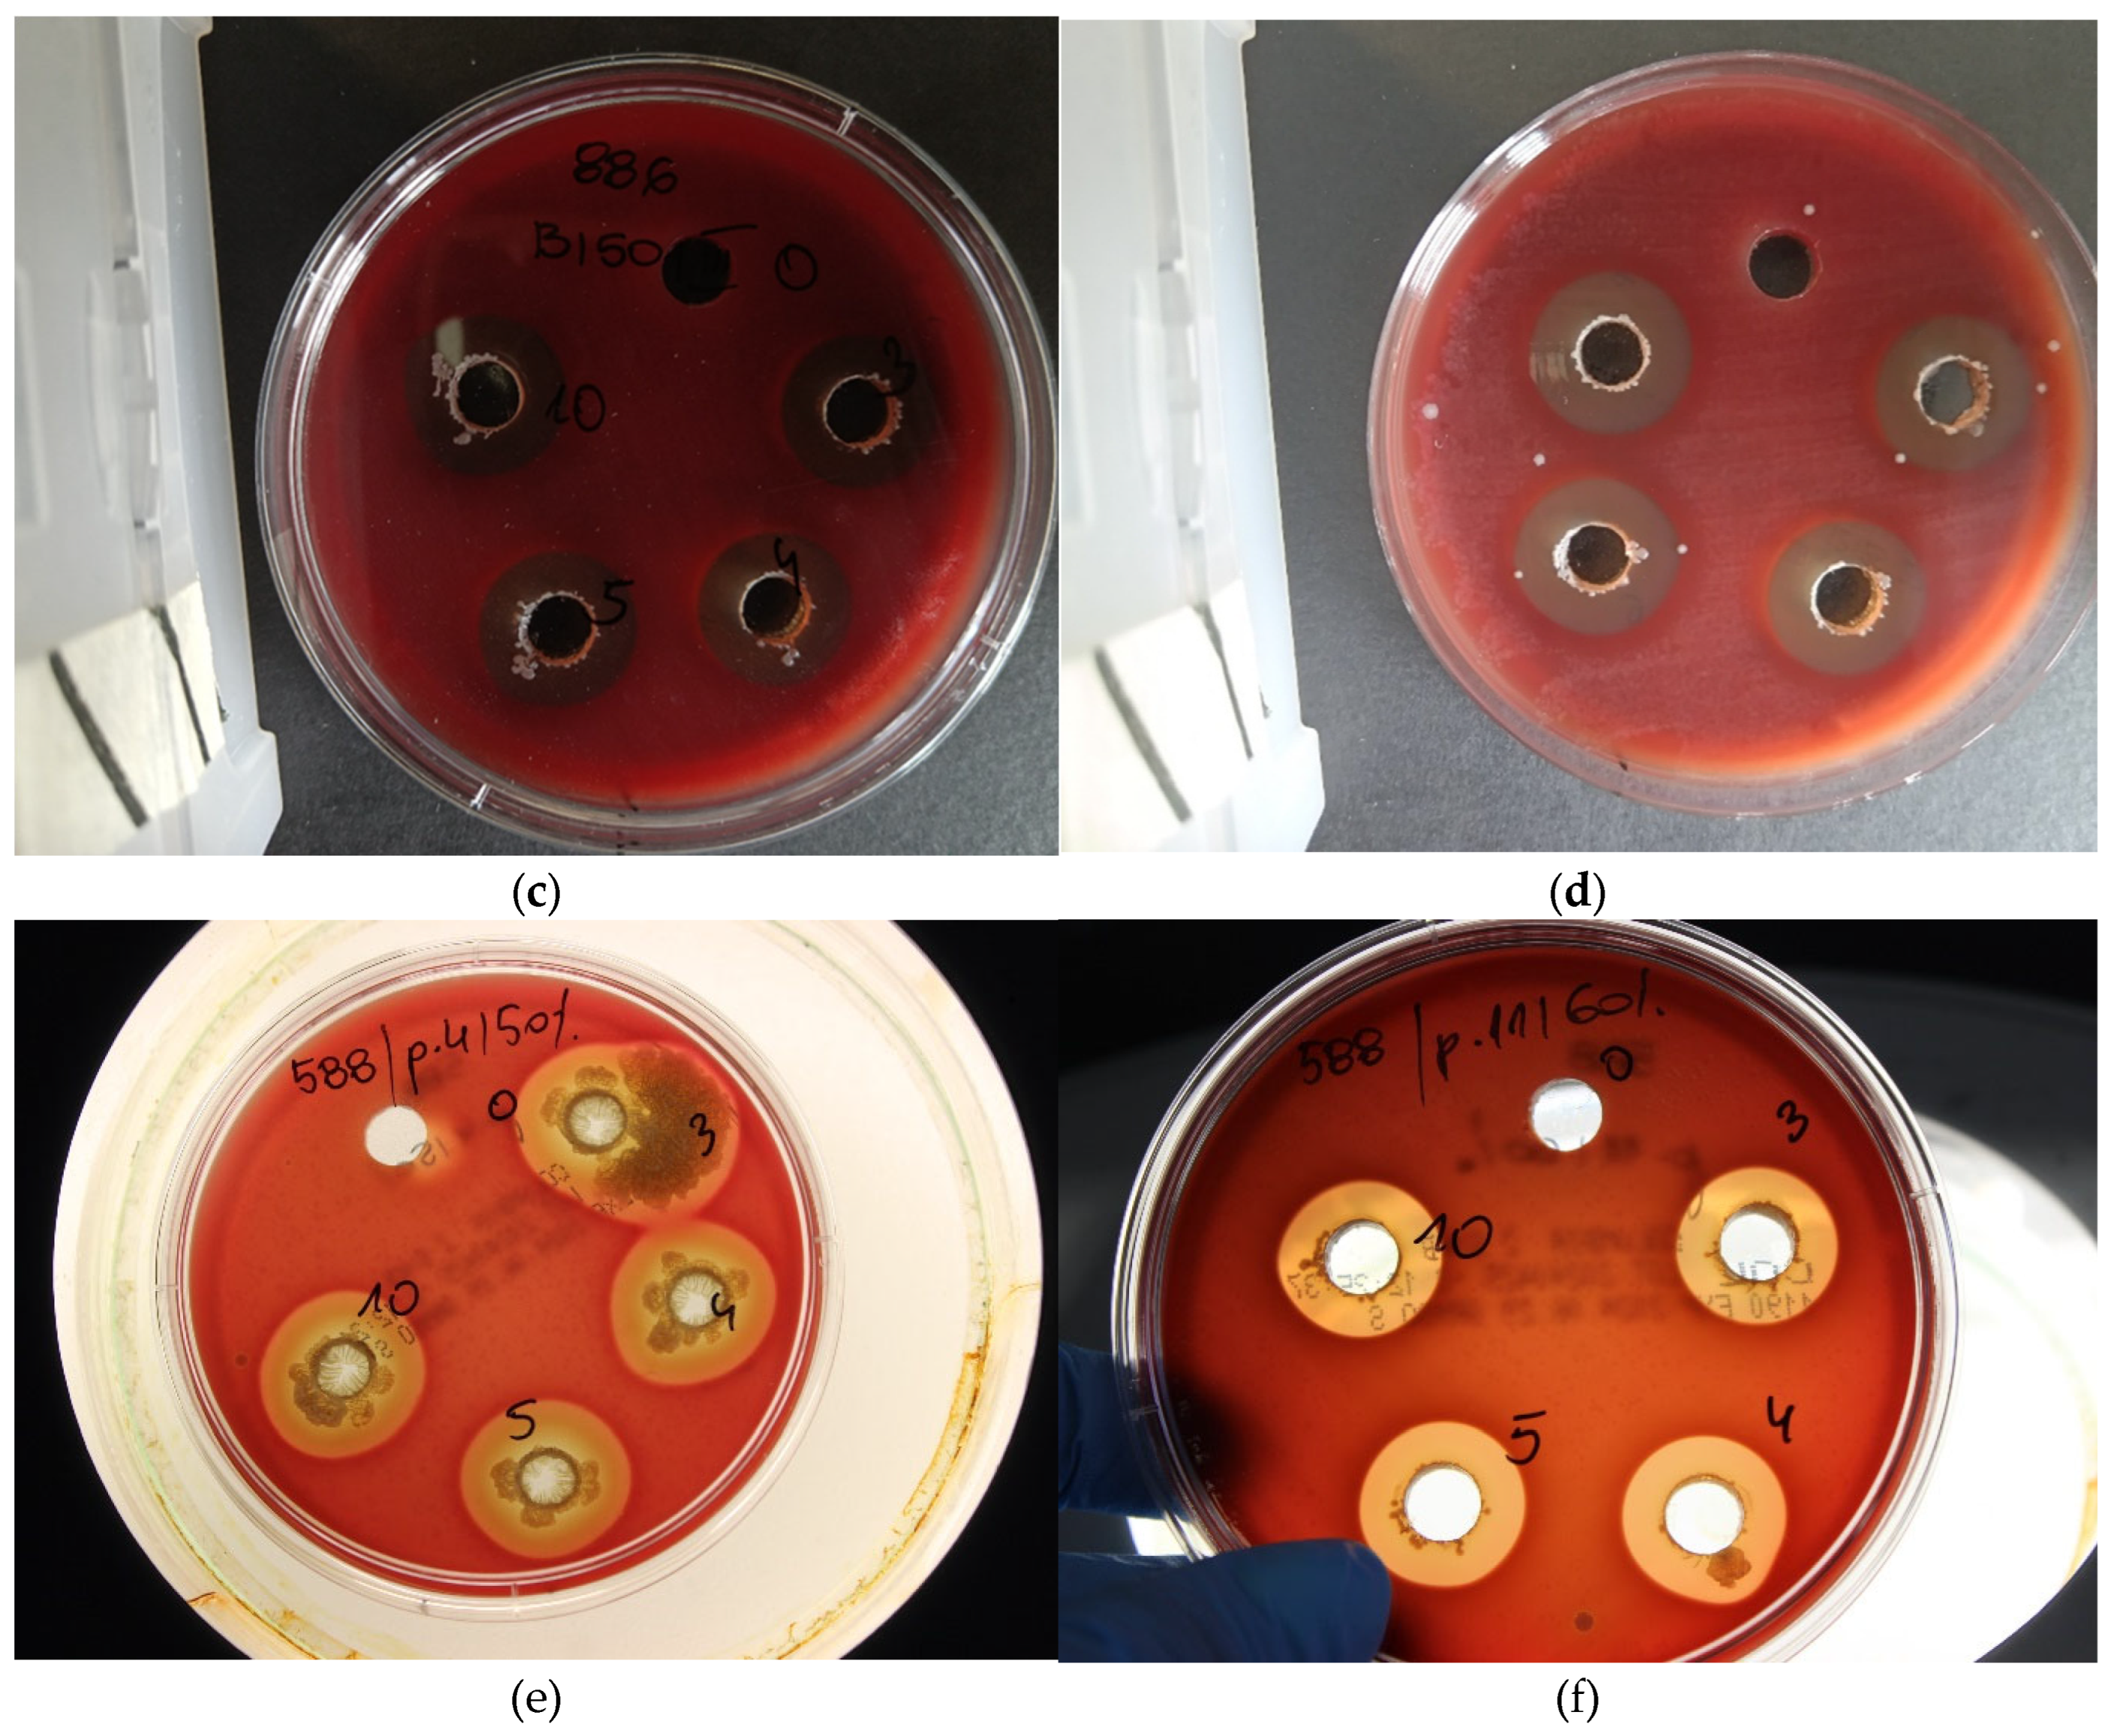
Preprints 119735 g003b

1. Introduction
The work of honeybee workers for humans and the ecosystem is invaluable. EFSA reports that the annual pollination by bees has been valued at around 22 billion Euros, and in Poland alone, this value exceeds 964 million Euros [
1,
2]. Worldwide, the economic value of pollination with honeybee workers has been estimated at 265 billion Euros per year [
3,
4]. Other sources report that the global value of pollination involving honeybee workers is estimated to be between US
$ 235-577 billion and up to half a trillion dollars [
5,
6,
7,
8]. Researchers have been searching for many years for factors that reduce losses in apiary management and increase the security of the honeybee as the main pollinator in the food production chain [
9,
10,
11]. Bee colonies are constantly threatened by brood and adult bee diseases, susceptibility to xenobiotics (including pesticides), an impoverished forage base, lack of diverse protein food resulting in massive worker malnutrition (nutritional stress), environmental stress, and newer and newer pests arriving from different parts of the world (populations of the small hive beetle or Asian hornet) [
12,
13]. The honey bee is also accompanied by a microflora whose biodiversity is modified by many environmental factors, including stress factors such as pesticides, forage shortages, pressure from the pathogenic microbiome, and immune impairment [
14,
15,
16]. According to various literature sources, there are between 6,000 and 8,000 different microbial strains in the microbiome of bee colonies [
17].
One microbial threat to the balance of the colony microbiome is
Paenibacillus larvae—a Gram-positive, peridomestic, mobile, virulent, spore-forming larvae that cause a brood disease called American foulbrood [
18]. The bacteria
Paenibacillus larvae, which produces approximately one billion spores per infected larva, is the main vector of this disease [
19]. Only spores can cause infection. Spores can survive for up to 50 years under favorable conditions and exhibit infectious properties for 35 years. A temperature of 100°C destroys spores after 5 days, while at 140-170°C they die after only 2 hours. Spores are also killed in 5-10% formalin within 6 hours, while soda lye kills spores at a concentration of 2% within 4 minutes. 5% sodium hypochlorite is also effective. Vegetative forms die at 60°C [
20,
21,
22]. An infected and disease-dead larva can contain up to 2.5 billion endospores, but only 10 to 35 spores are needed to infect another larva, indicating high virulence and a high rate of disease spread [
23,
24]. Spores can reside in honey, wax, royal jelly, propolis, pollen, and bee feathers. Once in the digestive tract of the larvae, they germinate after 24 hours, leading to bacterial superinfection manifested by rapid growth of vegetative forms. The vegetative cells damage the epithelium and intestinal walls and later attack all internal organs leading to cytolysis and histolysis [
25,
26,
27]. Nine days after infection, spores begin to form. The maggots die after 2-3 days after the cell is sealed [
28]. The dead larvae become flaccid, changing color first to yellow, then to a brown, sticky, and malleable mass. Five serotypes of American foulbrood are currently recognized worldwide: Eric I, Eric II, Eric III, Eric IV, and Eric V [
29,
30].
The epizootiological agent for all varieties remains the same bacterial species:
Paenibacillus larvae. Sick bee colonies are physically eradicated on the recommendation of veterinarians, legislation in the EU does not allow the use of any form of pharmacotherapy, and in Poland, American foulbrood is eradicated ex officio. In the past, antibiotics and sulphonamides were used. Currently, only administrative procedures are available for American foulbrood control [
31]. Once American foulbrood is confirmed, the district veterinarian may decide to eradicate the colonies or, in justified cases, order a double relocation procedure to a new or decontaminated hive on frames with hoses [
32]. Most cases with confirmed cases of foulbrood are classified as a high-risk group and end up with the burning of infected colonies. Prevention consists primarily of maintaining appropriate sanitary standards involving, for example, frequent changes of combs, and disinfection of hives and tools (e.g., with Virkon S). Other prevention methods include descriptions of the use of essential oils: cinnamon, rosemary, thyme, lemon or aniseed. The effect of extracts of various herbal species on
P. larvae cells is also known from in vitro laboratory studies [
33,
34]. Solutions described as effective in reducing
P. larvae abundance include products to be applied as food additives (syrup or cake) and products to be applied as sprays or sprinkled on the inter-frame streets [
35].
The Institute of Veterinary Medicine in Poland reports that
P. larvae spores are present in between 23 and 45% of the cases analyzed. Infected colonies weaken very quickly, the number of spring decreases dramatically leading to so-called colony unsealing, the number of bees decreases, which leads to a reduction in the economy of the farm or the total liquidation of the apiary. Statistical data from the Veterinary Inspectorate in Poland indicates several hundred cases of detected outbreaks, but these data are unreliable and underestimated and differ from the actual state. In previous years, i.e., 2009-2011, screening for the occurrence of
Paenibacillus larvae in bee colonies was carried out in 162 districts belonging to 9 voivodships. 6 510 honey samples were taken from 32 550 bee colonies from 2 294 apiaries. The disease was diagnosed in 45% of all apiaries examined, and the greatest intensity occurred in the Małopolskie voivodeship. In the Warmińsko-Mazurskie voivodeship, the presence of the bacteria was confirmed in 58% of the apiaries examined. Between 26% and 47% of apiaries were contaminated with
P. larvae spores [
36]. An even earlier history of the occurrence of American foulbrood in Poland is described in research studies conducted in 2005 and 2007. In 2005, out of 142 samples, 34 tested positive for
P. larvae, meaning that the bacteria were present in 23% of all samples. Similar statistics were found in 2007, where 23 out of 100 tests were positive. The number of Aedospores in 1 gram of honey ranged from 10 to more than 1,000. Such a huge scale of infections, still increasing from year to year, shows that the Polish beekeeping environment requires and needs the immediate implementation of a solution to reduce the uncontrolled growing number of infections in apiaries by supporting the bees’ natural protective barriers and stimulating increased nest hygiene [
37]. The data obtained from the above-mentioned monitoring indicates a growing problem with
P. larvae in bee colonies, which promotes the increasing incidence of American foulbrood. A high microbial burden on bee colonies is also observed in other countries, with a high number of infections also recorded in Austria [
38].
Currently, the number of bee colonies in Poland is 2.35 million, so this is a threefold increase since 2005 (827.4 thousand bee families). Bee families are looked after by around 97,000 beekeepers. The average bee colony per km
2 is 7.50. Unfortunately, the ever-increasing degree of apiculture in Poland favors the circulation of diseases between bee colonies [
39]. As of today, there are only 61 Veterinarians in Poland with a specialization in diseases of commercial insects [
40]. In Poland, there are no specific legal restrictions on the movement of migratory apiaries, which exacerbates the epidemiological situation.
The phenomenon of competition between microorganisms is well-known. Bacterial metabolites, also known as metabiotics, have become an object of scientific interest in recent years. Micro-organisms isolated from the digestive tracts of bees with in vitro antimicrobial activity against
P. larvae have been described in the literature [
41,
42]. Such activity may be called bioassurance. The definition given by Zygmunt Pejsak includes specific indications to be implemented to reduce or eliminate the risk of pathogen transmission into the flock. The aim of bioassurance is, among other things, to reduce the risk of introducing an infectious agent into the herd [
43]. In the definition of another researcher Thomas Gillespie, bioassurance must reduce the risk of pathogen intrusion and must consist of bioexclusion, which will control the transmission of pathogens. This element of bioassurance has been referred to as biocontainment [
44]. Bioassurance is the so-called biological protection consisting of protecting the animals through preventive and sanitary measures using biocontainment on the farm as well as in the immediate surroundings [
45,
46]. Adherence to bio-assurance aims, among other things, to reduce the incidence of pathogens and to improve animal health. Bioassurance is a set of measures aimed at maintaining or improving the health status of a herd through the use of specific organizational methods [
47,
48]. In other words, it is the biological protection of the farm. Effective bioassurance gives protection to the herd against the transmission of infectious agents [
49,
50,
51,
52]. Also, the Cambridge English Corpus states that these are the methods that are used to stop a disease or infection from spreading from one person, animal, or place to others or actions that are taken to prevent damage from biological threats using biological methods [
53]. Biotisation as a tool for the introduction of bioassurance may be a new biotechnological approach to animal husbandry. It consists of inoculating the animal environment with beneficial micro-organisms such as fungi or bacteria to increase their dominance in the environmental microbiome by increasing the tolerance of animals to biotic and abiotic stresses (in practice this is spraying or fogging). Biotisation is the process of inoculating with symbiotic native bacteria (bacterization) or involves the introduction of beneficial fungi-yeasts (microzation) [
54,
55]. Beneficial micro-organisms also known as beneficial or effective microorganisms (EM) have an important function in restoring the microbial balance in the native microbiome of animals and also supply animals with valuable metabolites and protect them from pathogens. Biosanitisation is a process that seeks to eliminate as many pathogenic microorganisms as possible, most commonly on flat surfaces and in the animal environment. Sanitization is carried out using common cleaning agents or biopreparations. This process does not guarantee the sterility of the cleaned object but allows the degraded and sterilized animal microbiome to be inoculated and rebuilt [
56,
57]. In the case of bee colonies, this can include inoculation of nests and hives with probiotics as a permanent integral part of good beekeeping practice. Bacteriophage therapies appear to be some kind of innovation in reducing
P. larvae infections, but phages are not officially authorized for use in Europe [
58].
The lack of effective product solutions on the market to prevent the development of superinfection, the unstable administrative and legal status of American foulbrood, the risky practices of beekeepers and growers exacerbating the American foulbrood problem, the increased interest on the market in natural products like targeted microbial biopreparations with increased metabolite content, the untapped potential of biotechnology and microbiology in the control and prevention of livestock diseases and animal welfare are just some elements of why this topic of work was undertaken.
4. Discussion
In nature, the phenomena of competition and induction of antagonism between microorganisms are well known. Targeted microbial biopreparations for agriculture and wastewater treatment plants, metabolic preparations with targeted stimulatory effects in veterinary medicine, or targeted probiotics in supplementation and therapeutics with a strict therapeutic purpose and effect are of increasing interest. The approach to the gut microbiota and the environmental microbiome has changed dramatically in the last 40 years. Unfortunately, as a result of various factors, this microflora is constantly being depleted, which justifies the regular use of probiotics to restore the degraded microflora. In line with the provisions of the European Field-to-Table Strategy and the Green Deal, a reduction in the use of antibiotics in the ecosystem cycle is recommended. This is also indirectly related to increasing antibiotic resistance [
70,
71].
Also in the environment of the honey bee population, there is a continuous reduction of beneficial microbes. Despite prohibitions, beekeepers quite often use prohibited antimicrobial substances, including antibiotics, which then easily pass into bee products and become a real threat to consumers in the food safety chain. To overcome these problems, steps should be taken to develop a leak-proof prevention system and to implement natural product solutions, which could contain proven functional microorganisms, metabolites, or plant extracts to displace and reduce the pressure of pathogens from the bee colonies’ physiological microbiome. The research undertaken in this study has achieved TRL Technology Readiness Level IV and will certainly continue to develop an effective composition to reduce bacterial superinfections caused by Paenibacillus larvae, together with a methodology for the application of such selected care products in beekeeping practice.
The development of American foulbrood and its milder variant, European foulbrood, caused by the bacterium
Melissococcus plutonius, mainly occurs in stressful situations, when malnutrition and starvation occur in the bee colony. Endospores of
Paenibacillus larvae and
M. plutonius begin to germinate and transform into vegetative forms of the bacteria when the glucose concentration in the simple intestine of the honeybee larva falls below 2.5 %. Certainly, the conditions for the development of any bacterial or fungal brood disease are linked to a disruption of the hive microflora, which, as a result of undetermined factors, has been reduced to such an extent that the spread of American foulbrood bacteria occurs at an extremely fast rate, leading to an exponential logarithmic growth of vegetative forms. American and European foulbrood bacteria are proteolytic pathogens, meaning that they rapidly lead to cytolysis and histolysis of the bee larvae. When the hive has a shaky, impoverished microbiome, even the smallest number of spores delivered to the hive with frames or through bee trophallaxis can lead to the expansion and domination of the hive environment by
P. larvae [
72,
73,
74].
Beekeepers’ use of mite killers to reduce the population of the bee tormentor
Varroa destructor also has a large impact on the significant reduction of the beneficial hive microflora. Such agents include acaricides, pyrethroids, organic acids, thymol, or organophosphate insecticides [
75].
The problem is global and also affects regions where antibiotic treatment is allowed. The pharmacokinetics of an antibiotic usually ends when one or, less frequently, two of the active substances are depleted or degraded, causing bacteria to rapidly acquire resistance to the active substance. In the case of probiotics, there is a specific fusion of many different biologically active substances with a complex structure and diverse mechanisms of action, which means that the bacterial cell is not able to produce as many defense mechanisms and provide resistance. Probiotic bacteria secrete a variety of phenol acids, flavonoid compounds, phenolic compounds, bacteriocins, antibiotics, organic acids, bioflavonoids, and biologically active compounds [
76,
77,
78].
Researchers searching for microbial antagonistic agents for American foulbrood biocontrol are most often limited to testing strains from the genera
Lactobacillus and
Bifidobacterium. Studies in which bacteria obtained from healthy bee colonies are isolated are also encountered. These are specific microorganisms derived from the microbiome of bee colonies and usually involve the genera
Bacillus sp., Streptococcus, Candida sp., Saccharomyces, Pseudobacterium, Fructobacillus, Parasaccharibacter, Ochrabactum, Acinetobacter, Stenotrophomonas, Gilliamella, Snodgrassella, Actinomadura, Streptomyces, Apilactobacillus, Bombilactobacillus and many others. As there are between 6,000 and 8,000 different microbial strains in the bee microbiome it seems nothing new or harmful to administer specific probiotics and supplement the microflora. In human medicine, the effect of so-called probiotic interventions and the administration of specific strains to support, for example, diabetes, cancer, or obesity, thus modifying the diseased microbiome, is increasingly being studied [
79,
80,
81,
82].
The results from the comparative analysis of the antimicrobial activity of culture fluids of selected probiotic bacterial species against
Paenibacillus larvae ser. Eric I and II under in-vitro conditions are consistent with literature data and tests evaluated by E. Forsgren, S. Lamei, and T. Olofsson [
83,
84,
85]
High efficacy in antimicrobial activity was also achieved in a 2006 study conducted by Alippi and Reynaldi, confirming high antimicrobial activity for
Bacillus pumilus, Bacillus licheniformis, and
Bacillus megaterium against
P. larvae ATCC 9545 [
86].
Audisio et al. described the effective combination of a
Bacillus subtilis strain with a plant extract against
P. larvae highlighting the high utility of
Bacillus spp. [
87].
Also Bartel and Alippi in 2018 identified natural antagonists of
P. larvae by selecting strains of
Bacillus species and related genera producing a broad range of antimicrobial compounds, with activity against bacteria and fungi that include peptides, lipopeptides, bacteriocins, and bacteriocin-like inhibitory substances. By using biological tools, they evaluated the antagonistic activity of 34 bacterial strains against
Paenibacillus larvae and
Ascosphaera apis, the causal agents of American Foulbrood and Chalkbrood diseases of honey bee larvae, respectively. In the work in question, a strong bactericidal effect attributed to a strain of
Bacillus megaterium and
Bacillus licheniformis was demonstrated. Similarly, in studies by other researchers,
B. megaterium showed strong antimicrobial activity due to the production of megacins by
Bacillus megaterium and also lichenin and lichenicidin produced by
Bacillus licheniformis [
88].
Studies by other authors have documented that
Bacillus licheniformis and another strain tested in the experiment reduced the mortality of American foulbrood-infected larvae. Treatments showed positive effects and reduced mortality [
89].
Many studies by other authors confirm the efficacy of the bacterial species analyzed in reducing American foulbrood. This demonstrates the pertinent and successful selection of bacterial strains that can find application in the prevention of this disease. In other studies,
B. licheniformis and
B. subtilis also showed antimicrobial activity against
P. larvae isolated from the bee environment in Saudi Arabia [
90].
There are no sources that report what antagonistic effect
Streptomyces narbonensis species may have. Korean researchers demonstrated that isolates extracted from forest soil, also identified as human pathogens, containing mainly strains of the genus
Streptomyces showed strong pressure and antimicrobial activity against
Paenibacillus larvae isolates supporting the theory that the source of the search for microbial agents need not only be the healthy bee microbiome but also other sources and natural resources [
91].
Bacterial metabolites are reported in great detail by Adrian A. Pinto-Tomas and co-workers, who isolated
Actinobacteria in the genus
Streptomyces from foraging bees, and especially common in pollen stores. One strain, isolated from pollen stores, exhibited pronounced inhibitory activity against
Paenibacillus larvae [
92].
Q. Jamal, on the other hand, describes the widespread use of bacteria of the genus
Lysinibacillus. Moreover, some
Lysinibacillus species have antimicrobial potential due to bacteriocins, peptide antibiotics, and other therapeutic molecules. Therefore, this review will explore the biological disease-fighting, food preservation, therapeutic, plant growth-promoting, bioremediation, and entomopathogenic potentials of the genus
Lysinibacillus [
93].
This shows a well-chosen vector of search and selection of strains for the work in question. Good probiotic properties, high survival rates, and origin from the hive microbiome are reported by Polish researchers in the context of
B. pumilus, and
B. licheniformis which again shows the correct selection in microbial agents for biocontrol of American foulbrood. It is therefore confirmed that
B. pumilus and
B. licheniformis species also occur in the hive environment [
94]
Levilactobacillus brevis also shows the ability to reduce the biofilm formation of
P. larvae isolated from honey bee guts or fresh pollen samples, as indicated by the mechanism of action of this species [
95].
In a study by Polish scientists,
Levilactobacillus brevis B50 increased the expression of pattern recognition receptors and genes encoding antimicrobial peptides (defensin-1 and abaecin [
96]. The LAB isolated from the honey bee gut has been demonstrated to be helpful for the inhibition of
P. larvae. The antibiotic action of
L. brevis is also based on its secretion of organic acids [
97,
98].
Figure 1.
Radar plot illustrating the distribution of tested inoculants with antimicrobial potential against Paenibacillus larvae ATCC 9545 ser. Eric I using the well-diffusion method [mm] according to EUCAST standards. Volumetric concentrations of 3%, 4%, 5%, and 10% were considered, the symbol ‘TP’ means tryptone-peptone medium, the symbol ‘M’ means reed molasses medium, the symbol ‘50% S’ means a 50% sucrose solution, the symbol ‘60% S’ means a 60% sucrose solution, the symbol ‘Mix’ means a consortium of all functional strains for a given experimental system.
Figure 1.
Radar plot illustrating the distribution of tested inoculants with antimicrobial potential against Paenibacillus larvae ATCC 9545 ser. Eric I using the well-diffusion method [mm] according to EUCAST standards. Volumetric concentrations of 3%, 4%, 5%, and 10% were considered, the symbol ‘TP’ means tryptone-peptone medium, the symbol ‘M’ means reed molasses medium, the symbol ‘50% S’ means a 50% sucrose solution, the symbol ‘60% S’ means a 60% sucrose solution, the symbol ‘Mix’ means a consortium of all functional strains for a given experimental system.
Figure 2.
Radar plot illustrating the distribution of tested inoculants with antimicrobial potential against Paenibacillus larvae CCUG 48973 ser. Eric II uses the well-diffusion method [mm] according to EUCAST standards. Volumetric concentrations of 3%, 4%, 5%, and 10% were considered, the symbol ‘TP’ means tryptone-peptone medium, the symbol ‘M’ means reed molasses medium, the symbol ‘50% S’ means a 50% sucrose solution, the symbol ‘60% S’ means a 60% sucrose solution, the symbol ‘Mix’ means a consortium of all functional strains for a given experimental system.
Figure 2.
Radar plot illustrating the distribution of tested inoculants with antimicrobial potential against Paenibacillus larvae CCUG 48973 ser. Eric II uses the well-diffusion method [mm] according to EUCAST standards. Volumetric concentrations of 3%, 4%, 5%, and 10% were considered, the symbol ‘TP’ means tryptone-peptone medium, the symbol ‘M’ means reed molasses medium, the symbol ‘50% S’ means a 50% sucrose solution, the symbol ‘60% S’ means a 60% sucrose solution, the symbol ‘Mix’ means a consortium of all functional strains for a given experimental system.
Table 1.
Reactor culture parameters for Bacillus pumilus R5 using: BPW (buffered peptone water), PCA (plate count agar), DRBC (dichloran rose bengal agar), MRS (De Man–Rogosa–Sharpe), ISA (iron sulfite agar), where symbol ‘G’ means growth and ‘NG’ means no growth.
Table 1.
Reactor culture parameters for Bacillus pumilus R5 using: BPW (buffered peptone water), PCA (plate count agar), DRBC (dichloran rose bengal agar), MRS (De Man–Rogosa–Sharpe), ISA (iron sulfite agar), where symbol ‘G’ means growth and ‘NG’ means no growth.
Table 2.
Reactor culture parameters for Bacillus licheniformis M/542/M/18 using: BPW (buffered peptone water), PCA (plate count agar), DRBC (dichloran rose bengal agar), MRS (De Man–Rogosa–Sharpe), ISA (iron sulfite agar), where symbol ‘G’ means growth and ‘NG’ means no growth.
Table 2.
Reactor culture parameters for Bacillus licheniformis M/542/M/18 using: BPW (buffered peptone water), PCA (plate count agar), DRBC (dichloran rose bengal agar), MRS (De Man–Rogosa–Sharpe), ISA (iron sulfite agar), where symbol ‘G’ means growth and ‘NG’ means no growth.
Table 3.
Reactor culture parameters for Streptomyces narbonensis R71 using: BPW (buffered peptone water), PCA (plate count agar), DRBC (dichloran rose bengal agar), MRS (De Man–Rogosa–Sharpe), ISA (iron sulfite agar), where symbol ‘G’ means growth and ‘NG’ means no growth.
Table 3.
Reactor culture parameters for Streptomyces narbonensis R71 using: BPW (buffered peptone water), PCA (plate count agar), DRBC (dichloran rose bengal agar), MRS (De Man–Rogosa–Sharpe), ISA (iron sulfite agar), where symbol ‘G’ means growth and ‘NG’ means no growth.
Table 4.
Reactor culture parameters for Lysinibacillus fusiformis E23 using: BPW (buffered peptone water), PCA (plate count agar), DRBC (dichloran rose bengal agar), MRS (De Man–Rogosa–Sharpe), ISA (iron sulfite agar), where symbol ‘G’ means growth and ‘NG’ means no growth.
Table 4.
Reactor culture parameters for Lysinibacillus fusiformis E23 using: BPW (buffered peptone water), PCA (plate count agar), DRBC (dichloran rose bengal agar), MRS (De Man–Rogosa–Sharpe), ISA (iron sulfite agar), where symbol ‘G’ means growth and ‘NG’ means no growth.
Table 5.
Reactor culture parameters for Levilactobacillus brevis M/495/M/17 using: BPW (buffered peptone water), PCA (plate count agar), DRBC (dichloran rose bengal agar), MRS (De Man–Rogosa–Sharpe), ISA (iron sulfite agar), where symbol ‘G’ means growth and ‘NG’ means no growth.
Table 5.
Reactor culture parameters for Levilactobacillus brevis M/495/M/17 using: BPW (buffered peptone water), PCA (plate count agar), DRBC (dichloran rose bengal agar), MRS (De Man–Rogosa–Sharpe), ISA (iron sulfite agar), where symbol ‘G’ means growth and ‘NG’ means no growth.
Table 6.
Reactor culture parameters for Bacillus megaterium R7 using: BPW (buffered peptone water), PCA (plate count agar), DRBC (dichloran rose bengal agar), MRS (De Man–Rogosa–Sharpe), ISA (iron sulfite agar), where symbol ‘G’ means growth and ‘NG’ means no growth.
Table 6.
Reactor culture parameters for Bacillus megaterium R7 using: BPW (buffered peptone water), PCA (plate count agar), DRBC (dichloran rose bengal agar), MRS (De Man–Rogosa–Sharpe), ISA (iron sulfite agar), where symbol ‘G’ means growth and ‘NG’ means no growth.
Table 7.
Data show antimicrobial activity against Paenibacillus larvae ATCC 9545 (ser. Eric I), using the well-diffusion method according to EUCAST standards [mm] with heat map effect (red color means low antimicrobial activity or lack of antimicrobial properties, green color means high activity).
Table 7.
Data show antimicrobial activity against Paenibacillus larvae ATCC 9545 (ser. Eric I), using the well-diffusion method according to EUCAST standards [mm] with heat map effect (red color means low antimicrobial activity or lack of antimicrobial properties, green color means high activity).
Table 8.
Data show antimicrobial activity against Paenibacillus larvae CCUG 48973 (ser. Eric II), using the well-diffusion method according to EUCAST standards [mm] with heat map effect (red color means low antimicrobial activity or lack of antimicrobial properties, green color means high activity).
Table 8.
Data show antimicrobial activity against Paenibacillus larvae CCUG 48973 (ser. Eric II), using the well-diffusion method according to EUCAST standards [mm] with heat map effect (red color means low antimicrobial activity or lack of antimicrobial properties, green color means high activity).